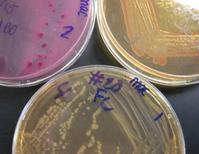

| ||||
MacConkey's Agar (MAC)
Differential & Selective Bacterial Growth Medium
When bacterial cultures are grown in a laboratory, they are growing in a captive environment, like a tiny microbial zoo. These captive-bred bacteria are totally dependent on people to provide the proper environment for their survival and growth. A nutrient-rich media is required to grow bacteria in the lab.
Article Summary: MacConkey's Agar is a specialized bacterial growth medium that is selective for Gram-negative bacteria and can differentiate those Gram- bacteria that are able to ferment lactose.
How to Interpret MacConkey's Agar (MAC)
MacConkey's Agar (MAC):
Growing E. coli (bright pink),
Enterobacter (pink margins)
& Salmonella (colorless),
clockwise from top left plate. More MAC images.
You have free access to a large collection of materials used in two college-level introductory microbiology courses (8-week & 16-week). The Virtual Microbiology Classroom provides a wide range of free educational resources including PowerPoint Lectures, Study Guides, Review Questions and Practice Test Questions.
 | ||||||
SPO VIRTUAL CLASSROOMS
Differential and selective media are special types of agar that can can exclude certain types of bacteria and even test for certain bacterial metabolic capabilities.
MacConkey’s (MAC), Blood agar (BAP) and Mannitol Salt (MSA) are three examples of these specialized types of media.
VIDEO: How to Interpret MacConkey's Agar (MAC) Bacterial Growth Medium
What is Bacterial Growth Media?
A growth medium (plural: media) is a mixture of nutrients, moisture and other chemicals that bacteria need for growth. Media are used to grow bacterial colonies (millions of bacteria having arisen through the binary fission of a single progenitor).
Using Media to Identify Bacteria
Like the differential staining of bacteria, special types of media can be used to provide clues about a microbe’s identity. There are many types of media that are specific about what they grow, or that provide information about the type of microbes present.
See Page 2 for
homework assignment
& other FREE teaching materials on Specialized Bacterial Growth Media!
Selective and Differential Media
If a bacterial growth medium is selective, that means that it grows only certain types of microbes while inhibiting the growth of others. Agar is considered a differential growth medium if, when specific microbes are present, the medium or bacterial colonies themselves exhibit a color change that provides information about their identity.
MacConkey's Agar Is Selective
MacConkey's is a selective medium that inhibits the growth of Gram-positive bacteria due to the presence of crystal violet and bile salts. Gram-negative bacteria grow well on MAC.
Sterile Specialized Bacterial Growth Media. Clockwise from top left MacConkey's,
Mannitol Salt and Blood Agar.
Continued ...
MacConkey's Agar Is Differential
MAC is also a differential, meaning that this medium differentiates or distinguishes between groups of bacteria on the basis of a color change reaction. MacConkey’s contains two additives that make it differential; neutral red (a pH indicator) and lactose (a disaccharide).
Sample from kitchen sink plated on Tryptic Soy Agar (front) and MacConkey's (back). Note bright pink coliform bacterial colonies.
 | ||||||